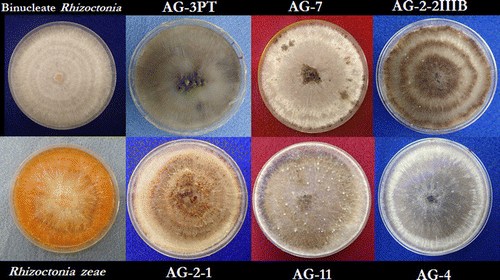

Identification and Characterization of Rhizoctonia Species A
发布日期:2020-11-16 12:29
来源:研究小组
作者:网络
浏览次数:
Olutoyosi O. Ajayi-Oyetunde and Carl A. Bradley
Abstract
In an effort to identify the Rhizoctonia spp. associated with seedling diseases of soybean, Rhizoctonia isolates were recovered from soybean seedlings with damping off and root and hypocotyl rot symptoms from Arkansas, Illinois, Kansas, Michigan, Minnesota, and the Canadian province of Ontario between 2012 and 2014. Based on cultural morphology, polymerase chain reaction restriction fragment length polymorphism, and phylogenetic analysis of the internal transcribed spacer (ITS) region of the ribosomal RNA genes, 80 isolates were confirmed to be Rhizoctonia solani, 24 were binucleate Rhizoctonia spp., and 10 were R. zeae. Of the 80 R. solani isolates, one belonged to anastomosis group (AG) 2-1, 52 belonged to AG-2-2IIIB, five belonged to AG-3 PT, three belonged to AG-4 HGI, two belonged to AG-4 HGIII, nine belonged to AG-7, and eight belonged to AG-11. Bayesian inference of phylogeny using the ITS region revealed two clades of R. solani AG-7 that possibly correspond to different AG-7 subgroups. Phylogenetic analysis also provided evidence for genetic relatedness between certain binucleate Rhizoctonia and some R. solani isolates. On ‘Williams 82’ soybean, isolates of AG-2-2IIIB were the most aggressive, followed by isolates of AG-7, AG-4, and AG-11. On ‘Jubilee’, a sweet corn cultivar, AG-2-2IIIB and AG-4 isolates caused significant stunting and root damage, whereas the damage caused by the AG-11 isolates was mostly restricted to the mesocotyl. Isolates of R. zeae and the binucleate Rhizoctonia spp. were not pathogenic on soybean or corn. Our results indicate that soybean and corn are hosts to the predominant and aggressive AG of R. solani, implying that rotation between these two crops may not be an effective management practice.
https://doi.org/10.1094/PDIS-06-16-0810-RE
 Fig. 1.Hyphal anastomosis reaction types for anastomosis group designation of Rhizoctonia solani isolates. C1 = cell wall contact only. C2 = cell wall fusion and death of anastomosing cells (killing reaction). C3 = perfect fusion of cell walls and cell membranes, and an absence of the killing reaction.
Fig. 1.Hyphal anastomosis reaction types for anastomosis group designation of Rhizoctonia solani isolates. C1 = cell wall contact only. C2 = cell wall fusion and death of anastomosing cells (killing reaction). C3 = perfect fusion of cell walls and cell membranes, and an absence of the killing reaction.
 Fig. 2.Microscopic and macroscopic characteristics of Rhizoctonia solani. A, Right-angled branching of septate hyphae. B, Dark-brown sclerotia of a growing colony on potato dextrose agar. C, Monilioid cells of sclerotia. D, Multinucleate Rhizoctonia. E, Binucleate Rhizoctonia.
Fig. 2.Microscopic and macroscopic characteristics of Rhizoctonia solani. A, Right-angled branching of septate hyphae. B, Dark-brown sclerotia of a growing colony on potato dextrose agar. C, Monilioid cells of sclerotia. D, Multinucleate Rhizoctonia. E, Binucleate Rhizoctonia.
 Fig. 3.Colony morphology of the binucleate Rhizoctonia, Rhizoctonia zeae, and some select anastomosis groups (AG) of Rhizoctonia solani.
Fig. 3.Colony morphology of the binucleate Rhizoctonia, Rhizoctonia zeae, and some select anastomosis groups (AG) of Rhizoctonia solani.

Self-Fueled Biomimetic Liquid Metal M
2015-03-27
Self-Fueled Biomimetic Liquid Metal Mollusk Authors Jie Zhang, Youyou Yao, Lei Sheng, Jing Liu Abstract A liquid metal motor that can eat aluminum food and then move spontaneously a...

“Click” reactions in polysacchari
2015-11-13
Xiangtao Meng a , b , Kevin J. Edgar a , b , , a Macromolecules and Interfaces Institute, Virginia Tech, Blacksburg, VA 24061, United States b Department of Sustainable Biomaterials...

A New Golden Age of Natural Products
2016-07-23
Ben Shen DOI: http://dx.doi.org/10.1016/j.cell.2015.11.031 The 2015 Nobel Prize in Physiology or Medicine has been awarded to William C. Campbell, Satoshi Omura, and Youyou Tu for t...

中国丝状真菌次级代谢分子调
2019-04-18
遗传, 2018, 40(10): 874-887 doi: 10.16288/j.yczz.18-169 综述 中国丝状真菌次级代谢分子调控研究进展 潘园园,1, 刘钢,1,2 1. 中国科学院微生物研究所,真...